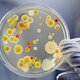
Micro

-
 Nació en Delft, Holanda. Comerciante en lencería. Descubrió y describió seres vivos músculos que denominó como "animalículos".
Nació en Delft, Holanda. Comerciante en lencería. Descubrió y describió seres vivos músculos que denominó como "animalículos". -
 Científico inglés. Describió la estructura fina del corcho y de materiales vegetales, utilizó por primera vez la palabra célula. Diseñó el microscopio compuesto rudimentario.
Científico inglés. Describió la estructura fina del corcho y de materiales vegetales, utilizó por primera vez la palabra célula. Diseñó el microscopio compuesto rudimentario. -
 Apoyó la generación espontánea llamada también abiogénesis
Apoyó la generación espontánea llamada también abiogénesis
Abio: sin vida, génesis: origen. -
 Se le reconoce como el padre de la inmunología.
Se le reconoce como el padre de la inmunología. -
 Inoculó a humanos con material de pústula de viruela (vaccinia).
Inoculó a humanos con material de pústula de viruela (vaccinia).
Comprobó con esta práctica la protección frente a casos de viruela humana. -
 Químico nacido en Dole, Francia.
Químico nacido en Dole, Francia. -
 Médico cirujano inglés.
Médico cirujano inglés.
Introdujo el uso del ácido fénico como desinfectante.
Utilizó la asepsia en la práctica quirúrgica.
Realizó cirugías bajo ambientes con desinfectantes pulverizados. -
 Enunciaron la teoría celular, definiendo a la célula como: la unidad básica estructural y funcional de la vida.
Enunciaron la teoría celular, definiendo a la célula como: la unidad básica estructural y funcional de la vida. -
 Estudió el carbunco. Postulados, inició cultivos puros y descubrió los agentes productores del cólera y la tuberculosis.
Estudió el carbunco. Postulados, inició cultivos puros y descubrió los agentes productores del cólera y la tuberculosis. -
 Trabajó con Pasteur.
Trabajó con Pasteur.
Demostró que los leucocitos fagocitan.
Relacionó la actividad de estas células con la defensa contra las enfermedades infecciosas.
Helicobacter pylori->Gastritis. -
 Observó en la sangre y en el bazo de animales enfermos, el bacilo del carbunco considerado como la primera bacteria relacionada con una enfermedad específica.
Observó en la sangre y en el bazo de animales enfermos, el bacilo del carbunco considerado como la primera bacteria relacionada con una enfermedad específica. -
 Estudió la fermentación por levaduras.
Estudió la fermentación por levaduras. -
 Sugirió el empleo del agar para los medios de cultivo (algas marinas).
Sugirió el empleo del agar para los medios de cultivo (algas marinas). -
 Culminó la generación espontánea
Culminó la generación espontánea -
 Inmunizó contra la rabia.
Inmunizó contra la rabia. -
 Sugirió servir en placas circulares los medios de cultivo.
Sugirió servir en placas circulares los medios de cultivo.
Looking for a timeline maker?
Create timelines for projects, roadmaps, history, lessons, legal cases, and stories with Timetoast. Timetoast is a timeline maker for work, school, research, and stories.